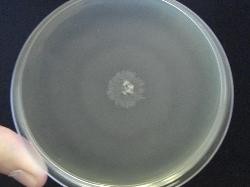
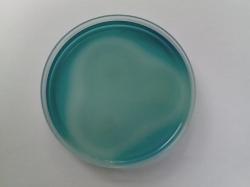

| Bacterial Motility |
The ability of bacteria to move independently using metabolic energy
depends on the use of different appendages to propel like flagella. The most
accurate way to visualize the moving bacteria is the microscopy and
'hanging drop method' is a commonly used microscopic technique: a drop of
fresh liquid culture is suspended on a clean glass slide, a coverslip is
added, and the culture is observed under microscope.
Media for motility demostration
Semisolid media like MIU or SIM allow the visualisation of bacterial motility
by medium stabbing method. Motility is positive if the entire medium became
opaque (semisolid state of the medium permits the bacteria moving). Result
is negative if the culture grows only on the stabbing line.
On Modified Semisolid Rappaport Vassiliadis medium (MSRV), the
semisolid state facilitates the motility of Salmonella. Detection is based on
the ability of Salmonella species to migrate in the selective medium by
competing with the other motile organisms, thus producing opaque halos of
growth.
Other types of movement occurring on solid surfaces include twitching,
gliding and sliding, which are all independent of flagella. Twitching motility is
used to move over surfaces and results from type IV pili activity which extend
from the cell's exterior, bind to surrounding solid substrates and retract,
pulling the cell forwards similarly to the action of a grappling hook.
Direct visualisation by microscope
1. Wet mount method:
Place one drop of broth bacterial culture or other liquid specimen (10 µl) on
a microscope slide then put a coverslip over. The examination should be
performed as soon as possible since the motility of some bacteria decrease
with temperature dropping or may become non-motile.
2. Hanging drop method:
It is a modification of the wet mount method where microorganisms are
suspended in a drop of fluid.
If a glass slide with a depression is not available the apply a paraffin ring or
adhesive tape ring to a clean glass slide to create a circular concavity. Hold
a clean coverslip by its borders and use a toothpick to dab vaseline on its
corners. Place a small drop of broth culture in the middle of the prepared
coverslip. Turn the prepared glass slide or concavity slide upside down so
that the drop of vaseline bonds the coverslip to the slide around the concavity.
Turn the slide over so the coverslip is on top and wait one minute for the
organisms to “settle.” The droplet may be seen suspended from the
coverslip over the concavity. Place the sample in the microscope slide
holder and using the diaphragm lever, adjust the light to enhance the
visibility of the cells.
Note: Brownian movement is not considered motility.
Video demonstrations of Salmonella, Helicobacter, Leptospira, Proteus and
Bacillus movements or swarming are available in Movies section.
depends on the use of different appendages to propel like flagella. The most
accurate way to visualize the moving bacteria is the microscopy and
'hanging drop method' is a commonly used microscopic technique: a drop of
fresh liquid culture is suspended on a clean glass slide, a coverslip is
added, and the culture is observed under microscope.
Media for motility demostration
Semisolid media like MIU or SIM allow the visualisation of bacterial motility
by medium stabbing method. Motility is positive if the entire medium became
opaque (semisolid state of the medium permits the bacteria moving). Result
is negative if the culture grows only on the stabbing line.
On Modified Semisolid Rappaport Vassiliadis medium (MSRV), the
semisolid state facilitates the motility of Salmonella. Detection is based on
the ability of Salmonella species to migrate in the selective medium by
competing with the other motile organisms, thus producing opaque halos of
growth.
Other types of movement occurring on solid surfaces include twitching,
gliding and sliding, which are all independent of flagella. Twitching motility is
used to move over surfaces and results from type IV pili activity which extend
from the cell's exterior, bind to surrounding solid substrates and retract,
pulling the cell forwards similarly to the action of a grappling hook.
Direct visualisation by microscope
1. Wet mount method:
Place one drop of broth bacterial culture or other liquid specimen (10 µl) on
a microscope slide then put a coverslip over. The examination should be
performed as soon as possible since the motility of some bacteria decrease
with temperature dropping or may become non-motile.
2. Hanging drop method:
It is a modification of the wet mount method where microorganisms are
suspended in a drop of fluid.
If a glass slide with a depression is not available the apply a paraffin ring or
adhesive tape ring to a clean glass slide to create a circular concavity. Hold
a clean coverslip by its borders and use a toothpick to dab vaseline on its
corners. Place a small drop of broth culture in the middle of the prepared
coverslip. Turn the prepared glass slide or concavity slide upside down so
that the drop of vaseline bonds the coverslip to the slide around the concavity.
Turn the slide over so the coverslip is on top and wait one minute for the
organisms to “settle.” The droplet may be seen suspended from the
coverslip over the concavity. Place the sample in the microscope slide
holder and using the diaphragm lever, adjust the light to enhance the
visibility of the cells.
Note: Brownian movement is not considered motility.
Video demonstrations of Salmonella, Helicobacter, Leptospira, Proteus and
Bacillus movements or swarming are available in Movies section.
| Twitching motility: migrating Moraxella colonies on Sheep Blood Agar |
| Antibiogram |
| Encyclopedia |
| Culture media |
| Biochemical tests |
| Stainings |
| Images |
| Movies |
| Articles |
| Identification |
| Software |
(c) Costin Stoica
| R E G N U M PROKARYOTAE |
| Back |
| Left: non-motile bacteria - growth on stabbing line. Right: motile bacteria - uniform medium turbidity. |
| Demonstration of Proteus swarming: waves of growing bacteria starting from a central point. |
| Halos around the three innoculation points produced by motile Salmonella on MSRV medium |